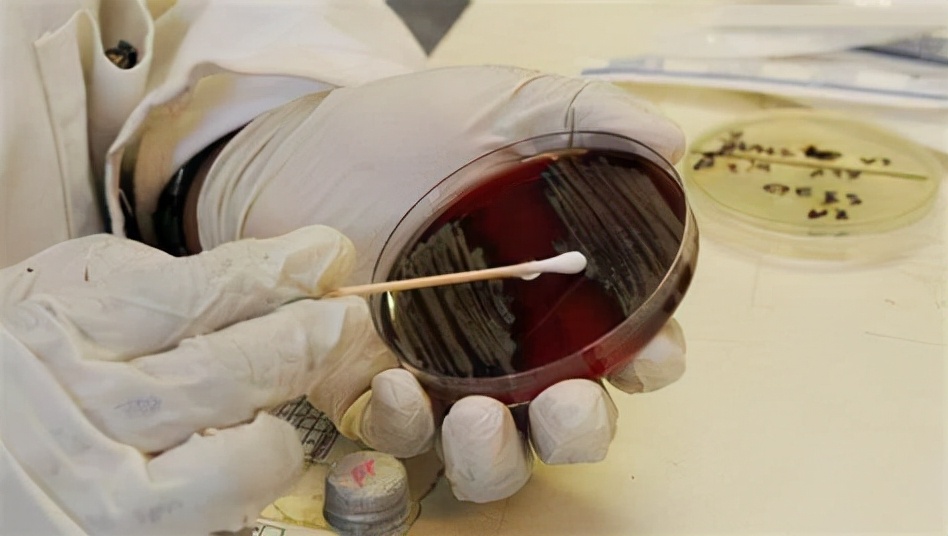
胆固醇|节约不好吗?医生提醒:贪小便宜吃大亏,小心4种“省”出来的癌

胆固醇|节约不好吗?医生提醒:贪小便宜吃大亏,小心4种“省”出来的癌

文章图片
文章图片

文章图片

当然没错 , 任何时候都不应该铺张浪费 , 而且我们国家也在提倡光盘行动 , 把盘子里的东西吃光才好呢 。
“过日子就要勤俭持家 , 绝对不能浪费 , 这种想法有错吗?”
可是要知道咱们说的是节约是节俭 , 可不是一毛不拔 , 一分钱都不花 。
为什么呢?其实很多时候癌症就是“省”出来的 , 平时这个不舍得 , 那个不想花钱 。
可是慢慢地 , 癌症发生的风险也会随之增高 , 为什么这么说呢?
今天我们就来一起看一下 , 那些省钱的地方 , 最终变成了增加癌症风险的关键 。
一、食物发霉舍不得扔 。我们都知道要珍惜粮食 , 都明白粒粒皆辛苦的道理 , 所以在生活中大家都非常珍惜粮食 。
这有错吗?一点错都没有 , 但是过分地节约就不对了 , 为什么这么说呢?
如果食物不新鲜或者发霉了 , 最好就不要吃 , 虽然扔掉确实很浪费 , 但是吃进肚子里所带来的风险会更大 。
比如花生发霉之后就可能感染黄曲霉素 , 黄曲霉素所产生的毒素可是一类致癌物 , 非常容易导致肝癌 。
类似的例子可不少 , 霉菌的致癌作用是很强的 , 如果碰到食物发霉的时候还是扔掉吧 , 别再吃进肚子里了 。
但是这么浪费是不是太过分了 , 其实我们在购买的时候一定要注意 , 绝对不要贪便宜买一大堆 , 最后要么自己强忍着胃部不适吃进肚子 , 要么就是一怒之下完全扔掉 , 可惜又浪费 。
二、不舍得花钱体检 。你有多久没体检了?不去体检是不是因为嫌贵呢?
这样的问题多问几个人 , 你一定会得到肯定的答案 , 很多人不去体检并不是因为害怕而是真的嫌贵 。
不可否认 , 有些检查项目确实是很昂贵的 , 很多人都没有办法负担得起 , 但这并不代表这就是我们不去体检的理由 。
既然有昂贵的项目就没有便宜的项目吗?当然有 。
即使是血常规 , 凝血象或者大生化 , 还都是相对廉价 , 而且可以做到初步筛查的检查项目 。
在体检这件事上最好不要太省钱 , 否则会付出惨重的代价 , 这样的例子比比皆是 , 相信你一定都听说过 。
不该省钱的时候要放开心 , 别再强求自己 。
三、不舍得用冰箱 , 怕费电 。真的有人觉得用冰箱费电吗?当然 , 而且这样的人是很多的 。
冰箱在我们的生活中是很常用的家电 , 我们可以把吃不完的食物放进冰箱 , 这样会延长食物的保存期 。
但是有些人觉得用冰箱的时候太费电了 , 于是明明有冰箱 , 也不舍得插电把食物放在常温的环境下 , 觉得放一宿或者两天 , 根本对食物没什么影响 。
殊不知 , 这给自己的健康带来了安全隐患 , 特别是在隔夜菜中 , 有一定的亚硝酸盐这些亚硝酸盐在存放12个小时之上 , 很有可能会慢慢变多 , 增加患癌风险 。
有冰箱就要用 , 既然冰箱都买了 , 干嘛怕花一小部分电费呢?
四、不该省时间 , 要多运动 。你有多久没运动了 , 每个人答案都不一样 , 但是很明显大多数人的运动量都不够 。
- 排毒|想长寿要会吃,三种蔬菜,常吃清理肠胃,排毒润肠,不妨一试
- 喝牛奶|为什么不建议女性天天喝牛奶?提醒:喝牛奶牢记4点,更营养
- 鸡蛋清性|每天晚上不妨多吃三种食物,营养丰富,延缓衰老,好吃又不贵!
- 肌肤|女性不愿老太快,坚持多吃3种食物,滋补身体,好处多多!
- 肝明目|秋冬常吃这3样益处多多,健胃促消化 ,营养不流失 ,吃了都说好
- 脂肪肝患者|脂肪肝能不药而愈?关于脂肪肝,这4个错误认知要避免
- 不要吃太饱 小心健康隐患
- 低脂饮食不等于清淡饮食
- 肠镜|肠镜选无痛好还是普通好?二者有何区别?不妨听听医生的分析!
- 疫情|切莫上当!这些都是流调员绝不会问的问题
